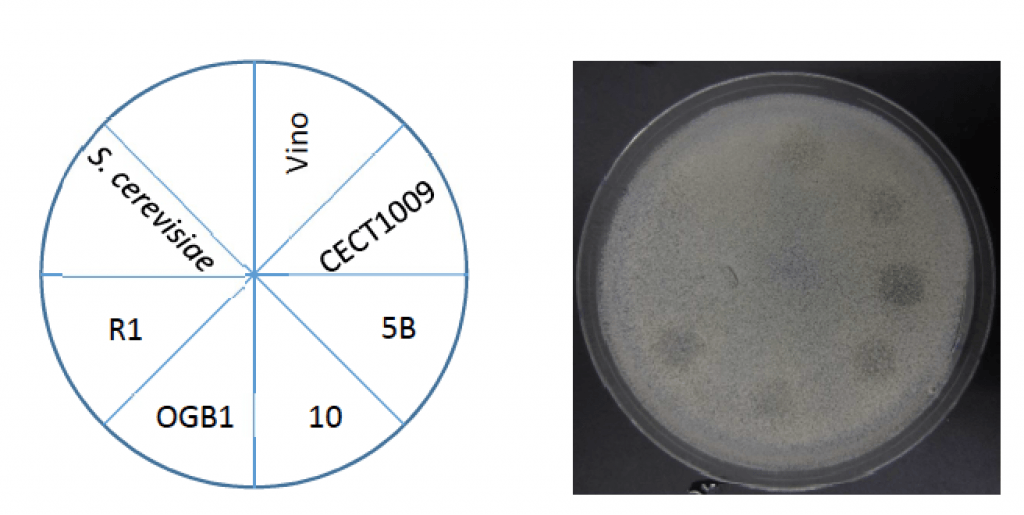

Secuenciación de amplicones y metagenómica
.jpg)
Secuenciación de amplicones y metagenómica
21/jul/23
8
min read
Cómo los análisis de suelo pueden diferenciar a los distribuidores
.webp)
Cómo los análisis de suelo pueden diferenciar a los distribuidores
08/feb/23
4
min read
Cómo Distribuidores Apoyan a Agricultores con Productos Biológicos
.webp)
Cómo Distribuidores Apoyan a Agricultores con Productos Biológicos
25/ene/23
4
min read
El papel de los hongos en la salud del microbioma del suelo

El papel de los hongos en la salud del microbioma del suelo
04/oct/22
4
min read
El microbioma del suelo y su impacto en la nutrición de las plantas

El microbioma del suelo y su impacto en la nutrición de las plantas
31/ago/22
2
min read
Oda al "the Pale Blue Dot"

Oda al "the Pale Blue Dot"
06/may/22
5
min read
La carrera del microbioma para medir la salud del suelo

La carrera del microbioma para medir la salud del suelo
06/may/22
4
min read
Una vacuna contra Brett
Una vacuna contra Brett
06/may/22
3
min read
El suelo, la fábrica de la vida

El suelo, la fábrica de la vida
28/abr/22
6
min read